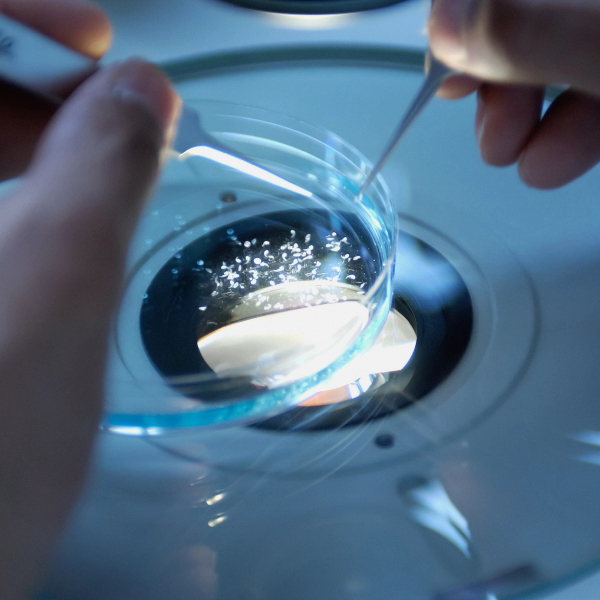

Precision-Driven Processes for Scalable, High-Quality Solutions
OmniBioPro specializes in designing, executing, and validating scalable processes and analytical methods tailored to your product’s unique requirements. From preclinical to commercial stages, we provide hands-on execution of laboratory work while collaborating seamlessly with your in-house teams, preferred partners, or leveraging our trusted network of CDMOs and CROs. We offer comprehensive product testing and development services to provide better biopharma products, including biosimilar and biobetter
Our Expertise Includes:
Scalable Process Design & Optimization
- Workflow Development: Creating scalable, efficient processes tailored to meet production demands while minimizing variability and waste.
- Advanced Testing Services: Includes stability analysis, forced degradation studies, and material testing to ensure robustness at all stages of development.
- Process Optimization: Upstream and downstream process refinement for clinical material production and scale-up.
- Comprehensive Product Development: Quality control, formulation development, and determination of product specifications to meet global regulatory standards.
- Technology Solutions: Technology evaluation, transfer, and implementation, including delivery device development and shelf-life determination.


Analytical Method Development
- Comprehensive Method Design: Developing, qualifying, validating, and executing robust analytical and biophysical methods to meet the needs of quality assurance, release testing, and regulatory compliance.
- Data-Driven Insights: Raw data analysis and results interpretation to support decision-making during development.
- Regulatory Alignment: Preparing technical documents and final reports aligned with FDA, EMA, and other global regulatory authorities.
- Tech Transfer to QC and Manufacturing: Ensuring seamless implementation of methods into quality control and manufacturing processes.
Process Validation
- Clinical to Commercial Scale: Ensuring consistent and reliable processes through rigorous validation from early-stage trials to large-scale production.
- Incident Investigation: Addressing deviations and ensuring corrective measures are implemented effectively.
- Control Strategies: Defining process controls and impurity evaluations for long-term success.

Collaborative Execution
- Flexibility in Delivery: Supporting development through in-house capabilities, preferred providers, or OmniBioPro’s trusted network of partners.
- CRO/CDMO/CMO Management: Assisting with vendor evaluation, strategy preparation, compliance auditing, and ongoing monitoring to ensure quality and alignment with project goals.
- Regulatory-Compliant Reports: Delivering finalized protocols, reports, and strategic documentation to meet global compliance standards.
Wet Lab Execution
- Comprehensive Laboratory Services: From product characterization and comparability to developmental stability, CQAs, and SFR analysis.
- Stability Studies: Conducting in-process, development, and GMP stability studies, including shelf-life and expiry date determination.
- Development Support: Pre-formulation and formulation development, delivery system optimization, and device integration for drug products.
- Technical Writing for Submissions: Preparing INDs, IMPDs, BLAs, and other regulatory documentation with precision.

